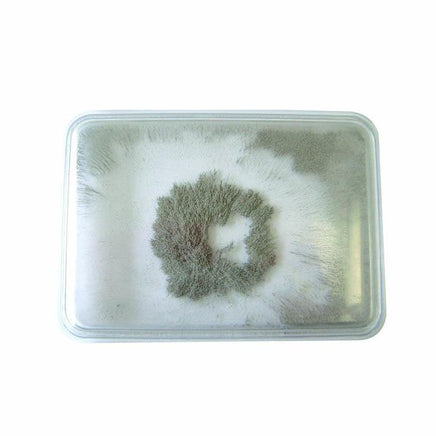

Iron Fillings Bubble
Edvantage
$4.20
Iron Fillings Bubble
Iron Filings Bubble. A rectangular, plastic-cased iron filings bubble which shows the effect of a magnetic force field when in proximity to a magnet. Size 97 x 70 x 10mm. A great addition to your science/exploration table to help introduce children to the wonders of magnetism.